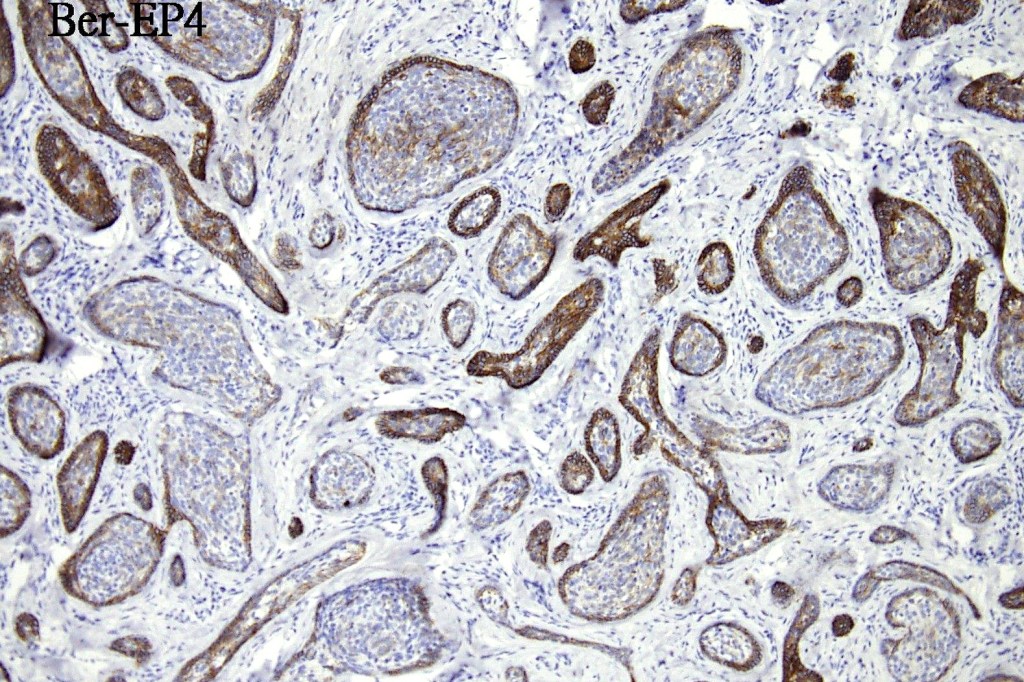
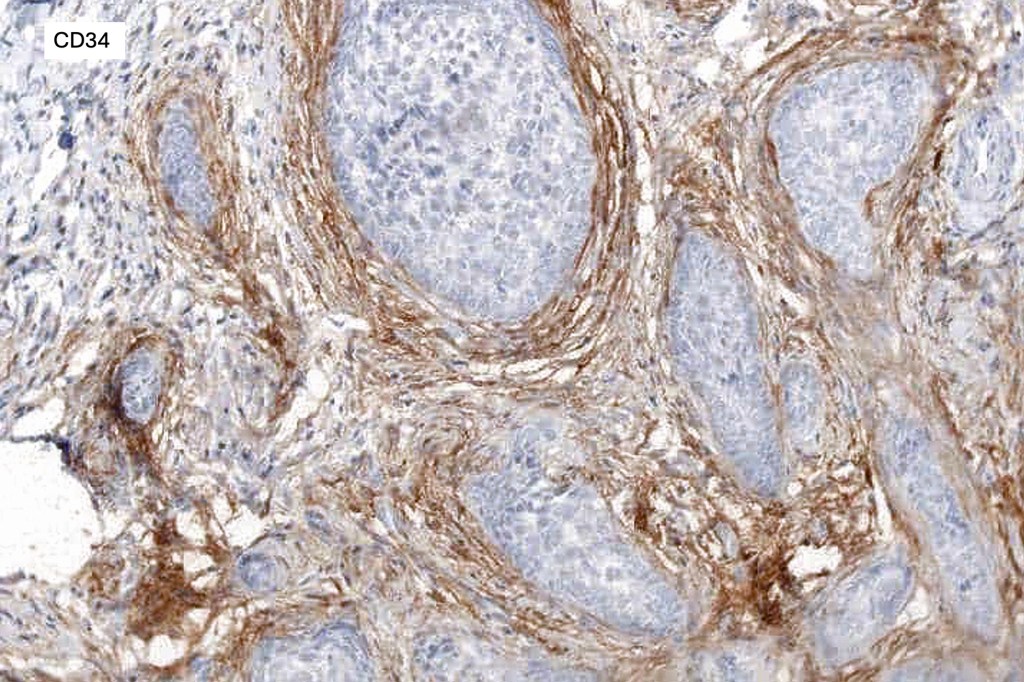

Considered by some authors to represent a variant of trichoblastoma (adamantoid trichoblastoma, lymphoepithelial tumor (not to be confused with lymphoepithelioma-like carcinoma)
Clinical features
•Solitary skin colored or erythematous papule, nodule or plaque up to 1.0 cm diameter
•Overlying telangiectasia may result in confusion with BCC
•Exceptionally multiple
•Predilection for the face (cheek, eyebrow, forehead)
•Exceptionally, neck, shoulder & leg
•Duration- 3 months-40 years
•M=F
•4th-5th decades (newborn-90 years)
•Benign (recurrence exceptional)

Histological features
•Dermal nodule, rarely extends into subcutaneous fat
•Irregular lobules of epithelial cells embedded in a dense fibrous stroma
•Peripheral rim of darkly staining basaloid cells surrounding larger pale staining cells with vesicular nuclei with often prominent eosinophilic nucleoli
•Central cells PAS positive (glycogen)
•No pleomorphism or mitotic activity
•No retraction artifact or stromal mucin
•Admixed lymphocytes (an obligatory feature)
•Germinal centers sometimes present
•+/- focal sebaceous differentiation (rare)
•+/- focal ductal differentiation (rare)
•Keratin & EMA +ve, CEA –ve
•Bcl-2 +ve peripheral epithelial layer, BerEP4 peripheral epithelial layer layer
.Stromal CD10 & CD34
•CK15, PHLDA1 & AR +ve has been described suggestion follicular stem cell differentiation
•T-cells>> B-cells (CD4>CD8)
•+/- Occasional CD30 +ve cells (Reed-Sternberg-like cells)
•+/- CK20 +ve Merkel cells
•S100, CD1a +ve Langerhans cells, CD68 +ve histiocytes
•1 exceptional case showing cutaneous lymphadenoma & cutaneous lymphoepithelial-like carcinoma (Dimitri Kazakov)

Leave a comment